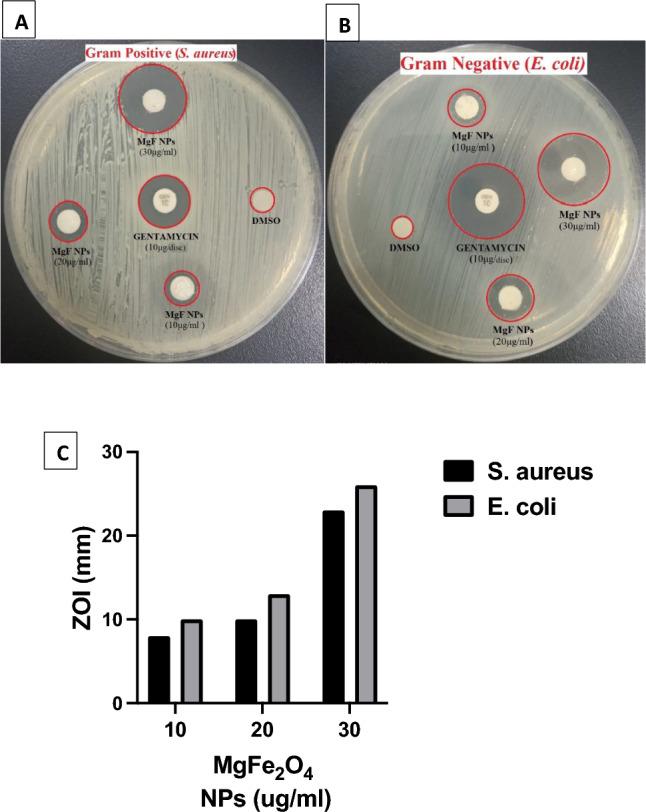
https://cdn.ncbi.nlm.nih.gov/pmc/blobs/db58/11150482/4a11fc442376/41598_2024_62868_Fig5_HTML.jpg

镁铁氧体磁性纳米粒子的光催化、抗菌和抗生物膜活性。
Photocatalytic, antimicrobial and antibiofilm activities of MgFeO magnetic nanoparticles.
机构信息
Department of Basic Medical Sciences, Faculty of Medicine, Galala University, New Galala City, Suez, Egypt.
Department of Microbiology and Immunology, Faculty of Medicine, Tanta University, Tanta, Egypt.
出版信息
Sci Rep. 2024 Jun 5;14(1):12877. doi: 10.1038/s41598-024-62868-5.
This study reports the antibacterial and antibiofilm activities of Magnesium ferrite nanoparticles (MgFeO) against gram-positive and gram-negative bacteria. The photocatalytic degradation of Carbol Fuchsin (CF) dye (a class of dyestuffs that are resistant to biodegradation) under the influence of UV-light irradiation is also studied. The crystalline magnesium ferrite (MgFeO) nanoparticles were synthesized using the co-precipitation method. The morphology of the resulting nanocomposite was examined using scanning electron microscopy (SEM), while transmission electron microscopy (TEM) was employed for further characterization of particle morphology and size. Fourier transform infrared (FTIR) spectroscopy and X-ray diffraction (XRD) were utilized to analyze the crystalline structure, chemical composition, and surface area, respectively. Optical properties were evaluated using UV-Vis spectroscopy. The UV-assisted photocatalytic performance of MgFeO nanoparticles was assessed by studying the decolorization of Carbol fuchsin (CF) azo dye. The crystallite size of the MgFeO nanoparticles at the (311) plane, the most prominent peak, was determined to be 28.5 nm. The photocatalytic degradation of 10 ppm CF using 15 mg of MgFeO nanoparticles resulted in a significant 96% reduction after 135 min at ambient temperature (25 °C) and a pH value of 9. Additionally, MgFeO nanoparticles exhibited potent antibacterial activity against E. coli and S. aureus in a dose dependent manner with maximum utilized concentration of 30 µg/ml. Specifically, MgFeO nanoparticles demonstrated substantial antibacterial activity via disk diffusion and microbroth dilution tests with zones of inhibition and minimum inhibitory concentrations (MIC) for E. coli (26.0 mm, 1.25 µg/ml) and S. aureus (23.0 mm, 2.5 µg/ml), respectively. Moreover, 10.0 µg/ml of MgFeO nanoparticles elicited marked percent reduction in biofilm formation by E. coli (89%) followed by S. aureus (78.5%) after treatment. In conclusion, MgFeO nanoparticles demonstrated efficient dye removal capabilities along with significant antimicrobial and antibiofilm activity against gram-positive and gram-negative bacterial strains suggesting their potential as promising antimicrobial and detoxifying agents.
本研究报告了镁铁氧体纳米粒子(MgFeO)对革兰氏阳性和革兰氏阴性细菌的抗菌和抗生物膜活性。还研究了在 UV 光照射下 Carbol Fuchsin(CF)染料(一类不易生物降解的染料)的光催化降解。使用共沉淀法合成了结晶镁铁氧体(MgFeO)纳米粒子。使用扫描电子显微镜(SEM)检查所得纳米复合材料的形态,而使用透射电子显微镜(TEM)进一步表征颗粒形态和尺寸。傅里叶变换红外(FTIR)光谱和 X 射线衍射(XRD)分别用于分析晶体结构、化学成分和表面积。使用紫外可见光谱评估光学性质。通过研究 Carbol fuchsin(CF)偶氮染料的脱色来评估 MgFeO 纳米粒子的紫外辅助光催化性能。在(311)平面上,最突出的峰,MgFeO 纳米粒子的晶粒度确定为 28.5nm。在环境温度(25°C)和 pH 值为 9 的条件下,使用 15mg MgFeO 纳米粒子对 10ppm CF 的光催化降解在 135 分钟后达到了 96%的显著减少。此外,MgFeO 纳米粒子对大肠杆菌和金黄色葡萄球菌表现出剂量依赖性的强抗菌活性,最大利用率浓度为 30µg/ml。具体来说,MgFeO 纳米粒子通过抑菌圈扩散和微孔稀释试验表现出显著的抗菌活性,对大肠杆菌的抑菌圈和最小抑菌浓度(MIC)分别为 26.0mm 和 1.25µg/ml,对金黄色葡萄球菌的抑菌圈和 MIC 分别为 23.0mm 和 2.5µg/ml。此外,10.0µg/ml 的 MgFeO 纳米粒子对大肠杆菌(89%)和金黄色葡萄球菌(78.5%)生物膜形成的抑制率显著降低。总之,MgFeO 纳米粒子表现出高效的染料去除能力,以及对革兰氏阳性和革兰氏阴性细菌菌株的显著抗菌和抗生物膜活性,表明其作为有前途的抗菌和解毒剂的潜力。